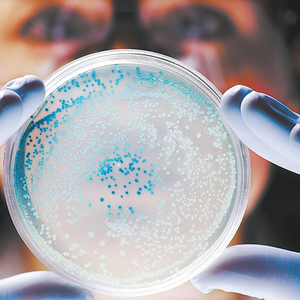

张田勘
近日,由中国与美国、澳大利亚研究人员组成的国际团队在《细胞》杂志上发表了一项研究成果,利用人工智能(AI)从全球微生物组中识别到近100万种潜在的抗菌肽(肽类抗生素),现已确认63种表现出对致病菌株的抑制效果。也就是说,新的抗生素可能因此被发现,以应对抗生素耐药性这一全球性难题。
致病菌对抗生素产生耐药性的主要原因是过度使用、误用和不合理使用抗生素,最严重的后果是导致超级耐药菌的出现。对此,世界卫生组织多次发出警告,如果这种情况持续下去,未来人类受到细菌感染时将无药可用。为此,全世界科研人员进行了诸多探索,并将主流研究方向集中在用人工智能筛选更多抗生素、研发有特定目标的“智能抗生素”、通过病毒(噬菌体)降低细菌致病力并阻止细菌产生耐药性上,以期找到抗生素耐药性的解决之道。

培养皿中的大肠杆菌
AI助抗生素加速研发
抗生素耐药性是一个全球性难题,是指微生物尤其是细菌耐受抗生素类药物,从而使药效打折扣甚至无效。
说到细菌耐药,研究人员首先想到的是研发更多新药,以避开细菌对老药的适应和耐受。但新药从研发到投入市场,通常需要10-20年时间和10亿美元以上的研究经费。现在,有了人工智能的帮助,新型抗生素的研发也进入了快车道。
相对于青霉素等传统抗生素,一类新型抗生素正受到科学家的青睐,这就是抗菌肽,又称为抗菌蛋白、肽类抗生素或天然抗生素,它们通常是具有抗微生物活性的小分子短肽。其实在过去几十年中,抗菌肽已成为强大的替代药物,满足了人们对新型抗感染药物的需求,以克服日益严重的抗生素耐药性问题。
现在,借助人工智能的机器学习方法,美国、中国和澳大利亚的联合研究团队在全球微生物组中,识别出近100万种潜在的抗菌肽。在选取其中有代表性的100种抗菌肽进行测试后,确认有79种具有体外活性、63种表现出对致病菌株的抑制效果,而且,这些致病菌株中有一些是超级耐药菌。
在这项新研究中,研究团队使用机器学习平台筛选包含微生物基因组数据库在内的多个公共数据库,分析了来自特定微生物的87920个基因组,以及来自环境样本的63410个微生物基因组混合物。最终,鉴定出来的物质涉及地球上生活于72种不同栖息地的微生物,其中,土壤/植物中的微生物占36.6%,水中的微生物占24.8%,人类肠道中的微生物占13%。
通过人工智能的帮助,研究人员鉴定了863498个候选抗菌肽,其中90%以上以前从未被描述过。为了验证这些发现,研究人员合成了100种抗菌肽,并测试了它们对11种致病菌株的作用,如金黄色葡萄球菌(含有耐药菌耐甲氧西林菌株)、鲍曼不动杆菌、肺炎克雷伯菌、大肠杆菌(含有一种耐粘菌素菌株)、铜绿假单胞菌、万古霉素耐药菌株粪肠球菌和屎肠球菌。
试验结果表明,有63种抗菌肽能完全抑制至少一种致病菌株的生长,有些抗菌肽在浓度很低时仍然具有抗菌活性,与现在临床使用的多粘菌素B和左氧氟沙星的抗菌效果相似。更令人鼓舞的是,一些耐药菌对这些抗菌肽尤其敏感,比如,分别有39种、24种、21种和26种抗菌肽对鲍曼不动杆菌、大肠杆菌、万古霉素耐药菌株粪肠球菌和屎肠球菌表现出抑制活性。
有一个问题是,虽然这些新筛选出来的抗菌肽对很多细菌有抑制作用,但是它们也与过去的抗生素一样,不具有专一性,会对很多细菌或所有细菌具有杀灭作用。这也意味着,新抗菌肽一旦研发出来用于临床,可以在一段时间内对抗耐药菌,但由于它们具有广谱性,会无差别杀灭细菌,所以未来依然可能让细菌产生新的耐药性。
“智能抗生素”可选择性打击致病菌
除了寻找新的抗生素外,解决细菌耐药的另一个重要举措是让抗生素具有专一性,而非广谱性,如此既能避免抗生素“滥杀无辜”,又能防止更多细菌产生耐药性。研究人员正在寻找和研发“智能抗生素”,只抑制和杀灭少数致病细菌,而不伤害其他对人和生物无害的微生物。
在现实生活中,革兰氏阴性菌引起的感染越来越普遍,引发的疾病包括肺炎、腹膜炎、泌尿道感染、血液感染、伤口或手术部位感染、脑膜炎等。对于大肠杆菌、变形杆菌、沙门氏菌、克雷伯氏菌、绿脓杆菌等革兰氏阴性菌导致的感染,临床通常采用广谱抗生素治疗,但这样做不可避免地会对肠道微生物组造成破坏,且容易产生继发感染,从而让革兰氏阴性菌变得越来越耐药。
现在大多数抗生素的靶点都是革兰氏阴性菌和革兰氏阳性菌(如芽孢杆菌、李斯特菌、葡萄球菌和链球菌等)所共有的。由于肠道微生物群中本就含有许多革兰氏阴性菌,不加选择地使用抗生素(如粘菌素),除了导致细菌耐药外,还可能引发严重的肠道生态失调。耐药的原因不外乎几种:天生就对某些抗生素耐药、从已耐药的细菌中获得基因转移而耐药、基因突变导致耐药。所以,研究人员希望针对革兰氏菌的耐药性研发新的非广谱抗生素。
研究人员把目标转向研发“智能抗生素”。美国伊利诺伊大学的研究团队研发了一种新型抗生素洛拉米星(Lolamicin),这是一种能靶向脂蛋白转运系统的革兰氏阴性特异性抗生素。初步试验结果表明,洛拉米星对130多种耐多药的细菌具有抑制活性,并对小鼠的急性肺炎和败血症感染显示出疗效。暴露于抗生素耐药细菌后出现血液感染的小鼠,在给予洛拉米星后全部存活,没有接受洛拉米星治疗的小鼠有87%在3天内死亡。而且,对小鼠使用洛拉米星后,其肠道微生物组还保留了下来,因此能防止因肠道微生物菌群失衡而导致的艰难梭菌继发感染。
革兰氏阴性菌的外膜由脂多糖、磷脂、外膜蛋白和脂蛋白等成分组成,是细菌抵御外界有害物质的主要物理屏障,与细菌致病性和耐药性密切相关。细菌外膜各成分依赖特定的系统进行跨膜转运,包括脂多糖转运系统、脂质不对称维持系统、β-桶状装配机器及脂蛋白定位系统等,这些系统能够保证细菌外膜的完整与稳定,被视为维持细菌生命活动的命门。换句话说,任何破坏细菌命门的物质都有可能成为抵御革兰氏阴性菌的药物。
洛拉米星的作用原理就是瞄准细菌的脂蛋白定位系统,这个系统是细菌外膜的重要组成部分,对各种革兰氏阴性菌至关重要。研究人员评估了洛拉米星对临床多重耐药菌株,如大肠杆菌、肺炎克雷伯菌和阴沟肠杆菌的疗效,并与其他药物进行了比较。与临床一线抗生素阿莫西林和克林霉素相比,洛拉米星对肠道微生物组的影响最小。同时,与对照组相比,使用洛拉米星的小鼠肠道中的艰难梭菌容易清除,而使用阿莫西林或克林霉素的小鼠无法清除艰难梭菌。这些情况表明,阿莫西林等常见抗生素会严重破坏动物的肠道微生物组,导致艰难梭菌感染,洛拉米星则不会引起肠道微生物组的显著变化,能使小鼠免于艰难梭菌感染。
以上研究结果表明,洛拉米星是一种比较专一的特异性抗生素,有可能最大限度地减少对肠道微生物群的损害,并能预防继发性感染,从这个角度看,符合“智能抗生素”的条件。不过,洛拉米星只是在动物试验中体现出了“智能”药效,在人体中是否有效还需进行人体试验的验证,如果能获得同样的结果,便有望在未来进入临床使用。届时,洛拉米星这样的“专一”抗生素将比目前临床使用的广谱抗生素有更大优势,能选择性地杀死致病细菌,而不会杀死非致病细菌、破坏肠道菌群的平衡。

病毒(噬菌体)瓦解细菌示意图
解除细菌耐药性还有新路径
致病菌对抗生素产生耐药性的另一个重要原因是细菌的基因适应了某些常用药物。比如,针对青霉素,有的细菌发展出了抗药基因,并且把这种耐药基因传递给了后代(垂直传递),同时,这种抗药基因也可通过基因载体(特别是质粒)携带,水平转移到其他细菌,引起更多的细菌耐受抗生素。此外,细菌耐受抗生素的机理还包括细菌膜对该抗生素的抗渗性;细菌对渗入抗生素的外排;通过对作用靶点的定量或定性修饰,降低抗生素与细菌靶点的亲和力;利用细菌酶使抗生素失活等。因此,科研人员只要找到上述机理的突破口,就可以破解抗生素耐药性的难题。
现在,美国得克萨斯农工大学的一个研究小组发现,使用侵袭细菌的病毒(噬菌体)可以让细菌失去耐药性,它还可以当成抗生素来使用,以抑制细菌的活性。这一结论基于对铜绿假单胞菌的研究。
铜绿假单胞菌是一种可以引起血液、肺部感染的细菌,也是目前比较顽固的耐药菌之一。人类是铜绿假单胞菌的宿主之一,细菌通常寄宿在人的腋窝和生殖器等部位,引起多种感染和疾病,如轻微的外部感染(耳朵或毛囊感染)、严重的内部感染(肺、血液、心脏瓣膜感染)。耐抗生素假单胞菌感染的流行,使得研究人员高度关注如何对付这种耐药菌。研究人员发现,铜绿假单胞菌之所以耐药,是因为它们彼此之间能传播抗药基因,并四处移动,导致更多的铜绿假单胞菌内形成难以被抗生素突破的生物膜结构。其中,一种被称为菌毛的附属物能帮助铜绿假单胞菌产生耐药性,并传播耐药基因。
有意思的是,有的病毒可以通过附着于铜绿假单胞菌的菌毛而感染细菌。研究人员利用荧光显微镜、低温电子显微镜和计算模型观察了一种名为PP7的病毒(噬菌体)是如何吞噬细菌的。PP7沾在菌毛上后,菌毛收缩并将其拉到细胞表面。在病毒进入的地方,菌毛会弯曲并折断,菌毛的丢失使铜绿假单胞菌感染宿主的能力大大降低。病毒感染铜绿假单胞菌后,会让后者的菌毛弯曲并丢失,这意味着,利用特定的病毒感染细菌,不仅能使细菌失去致病性,还会让细菌失去耐药性,因为细菌的菌毛可以在细菌之间传递耐药基因。
截至目前,研究人员已发现铜绿假单胞菌、大肠杆菌和不动杆菌3种细菌可以被特定病毒感染、损害菌毛,从而抑制细菌感染人和传递抗药基因的能力。种种迹象表明,治疗细菌感染不是只有抗生素这一条路,也可让噬菌体解除细菌的武装(如损坏其菌毛),使细菌失去感染宿主的能力。减少抗药基因通过菌毛在细菌之间传递,以降低细菌的耐药性,也便于医生用较低剂量的抗生素来治疗疾病。
面对抗生素耐药性这个全球性难题,人工智能筛选抗生素、研发“智能抗生素”、采用病毒(噬菌体)抑制细菌等主流研究方向目前取得的研究进展虽然尚处于动物试验阶段,但至少为人类解决抗生素耐药性提供了切实可行的路径和方向,值得继续探索。